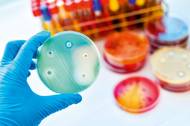

Češi to přehánějí s antibiotiky. Rezistence na ně by se mohla stát větším zabijákem než rakovina
Před 2 roky
Antibiotika ztrácejí účinek, a pokud budeme v jejich nadužívání pokračovat, bude v roce 2050 umírat více lidí na nákazu rezistentní bakterií než na rakovinu